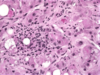

Test 2 Flashcards
(198 cards)
What’s the #1 cause of extrahepatic obstruction? What most often brings this about?
large duct obstrution is #1 cause of extrahepatic obstruction; LDO is most commonly caused by gallstones
What causes hereditary tyrosinemia?
deficiency of fumarylacteoacetate hydrolase (FAH)
Describe the inflammation associated with ulcerative colitis.
crypt accesses with neutrophils
How does pregnancy related cholestasis present?
•Presents with intolerable pruritus (worse in soles and palms and at night) and elevation in serum bile acids
Which liver cells play an important role in the development of fibrosis?
stellate cells; when activated, they make collagen= fibrosis
Primary sclerosing cholangitis causes destruction of which ducts?
extra- and intrahepatic ducts of all sizes
Use of which antibiotic in particular predisposes to C. difficile infection?
clindamycin (First Aid also says ampicillin)
What should be considered for recurrent c. diff?
probiotic (first aid says fecal microbiota transplant)
What are the key pathologic features of Nonalcoholic Fatty Liver Disease & Non-alcoholic Steatohepatitis (NASH)?
- Steatosis, often zone 3
- Lobular inflammation, mixed but often neutrophils
- Pericellular fibrosis and ballooning degeneration
- Fibrosis around individual hepatocytes
results from surgical resection of a large portion of the small intestine
short bowel syndrome
What’s the clinical presentation of Crigler-Najjar Syndrome?
presents within first 3 days of life with persistant jaundice and unconjugated hyperbilirubinemia. Can lead to kernicterus= bilirubin deposition in brain= severe neuro damage
What’s the treatment for Gaucher disease?
IV recombinant glucocerebrosidase
At what point is alcoholic fatty liver irreversible?
when fibrosis develops
What are the typical laboratory findings of alcoholic hepatitis?
- AST and ALT mildly elevated
- AST>ALT (usually 2:1 pattern for alcohol)
- markedly elevated bilirubin
- very elevated WBC
- elevated INR
What’s the main stay of treatment of colon cancer?
complete surgical resection
Describe the morphology of Clostridium difficile.
spore-forming, anaerobic, gram-positive bacillius
Iron deficiency anemia is common with colorectal cancer in which segment of the colon
right colon
What’s the best diagnostic test for ischemic colitis ?
sigmoidoscopy/ colonoscopy with biopsy
What WHVP, FHVP, AND HVPG values do you expect for presinusoidal liver disease?
- WHVP normal
- FHVP normal
- HVPG normal
What is this an image of?
alcoholic hepatitis demonstrating both Mallory’s hyaline and fatty change
A hepatic venous pressure gradient (HVPG) of what predicts increased risk of death?
> or = to 16
What is this an image of? How can you tell?

autoimmune hepatitis; Portal and periportal inflammation (hepatitis) with prominence of plasma cells
What are the features of Peutz-Jeghers syndrome?
numerous hamartomatous polyps throughout GI tract along with hyperpigmented mouth, lips, hands, and genitalia
What’s the treatment for C. Difficile?
metronidazole or ORAL vancomycin








